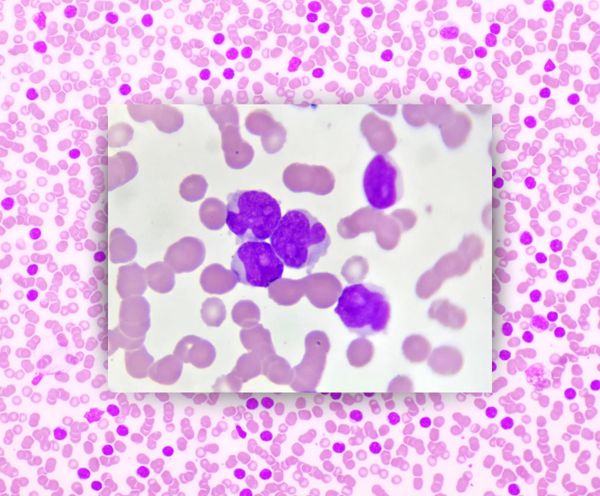
Leukemia 101

Day Zero: A Quick Update
Michael’s initial transplant happened as planned on Wednesday June 25, with a second transplant happening the following day on June 26th. Our youngest son Benjamin had three days of injections in the morning and evening to stimulate production of hematopoietic stem cells within his bone marrow, which were then